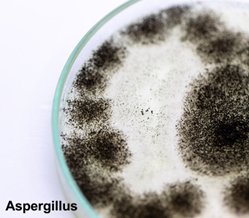
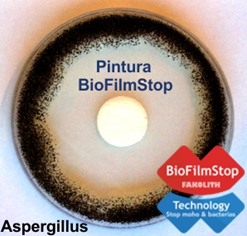

Publicado el 25-01-2019 por Fakolith Chemical Systems
Las superficies de cámaras o bodegas donde se almacenan o depositan los derivados de carne curada como jamones y embutidos son colonizadas por hongos filamentosos, levaduras y bacterias durante todo el proceso de curado y maduración.
Algunos de estos microorganismos, producen efectos positivos mejorando el nivel sensorial, ayudando a disminuir el enranciamiento, la oxidación o aportando precursores de compuestos volátiles característicos que enriquecen el nivel organoléptico.
Sin embargo, otros microorganismos pueden producir desde alteraciones organolépticas indeseadas, a micotoxinas que afectan a la seguridad alimentaria y por tanto a la salud de las personas.
La pinturas alimentarias y sanitarias de Fakolith contribuyen positivamente a prevenir la contaminación de superficies de la industria alimentaria, ya que estas son uno de los principales vectores de contaminación hacia el ambiente y hacia los alimentos.
1.- Un poco de historia

Las enfermedades causadas por las micotoxinas se conocen desde la Edad Media como el “fuego sacro”, aunque fue a partir de la segunda guerra mundial, cuando tras varios episodios importantes ocurridos en Europa y Japón, se activaron todas las alarmas.
A finales del siglo XX la comunidad internacional ya se tomó muy en serio el estudio de las intoxicaciones alimentarias producidas por micotoxinas. Hoy en día las autoridades sanitaras de los países más industrializados, (EFSA en la EU), han ido incrementando las exigencias regulatorias y fijando contenidos máximos de micotoxinas en los alimentos, como por ejemplo: Aflatoxina, Ocratoxina, Fusarium y Petulina.
2.- Mohos y Micotoxinas indeseadas
Las micotoxinas son metabolitos secundarios venenosos para las personas y animales.

Si bien es el sector primario (cereales y otros) donde se genera el mayor riesgo de contaminación por micotoxinas, también se pueden producir e incrementar el riesgo en el procesamiento y almacenaje de alimentos, especialmente por la presencia de hongos no deseados en las instalaciones alimentarias.
También se pueden producir en la propia superficie de jamones y embutidos en las diferentes etapas de maduración y curado, por algunos hongos de las familias Penicillium, Aspergilus, Cladosporium, Trichoderma, Curvularia, Eurotium…
Algunos de estos microorganismos producen efectos positivos, aportando precursores de compuestos volátiles característicos que inciden a nivel organoléptico, ayudando, como les venimos diciendo, además, a disminuir el enranciamiento, la oxidación, etc.
Sin embargo, otro tipo de hongos, pueden producir desde alteraciones organolépticas indeseadas, a micotoxinas que afectan a la seguridad alimentaria y por tanto a la salud de las personas.
Los hongos se caracterizan por su habilidad para desarrollarse también en superficies con una baja actividad de agua, e incluso con altas concentraciones de sal. Hay familias que además de producir micotoxinas como Fusarium, Cladosporium, Claviceps entre otras, también favorecen el desarrollo microbiano de bacterias Staphylococcus y levaduras del género Debaryomyces.
Las micotoxinas tóxicas al ser ingeridas, inhaladas o absorbidas a través de la piel pueden producir desde simples alergias a enfermedades muy serias.
3.- Factores de contaminación

Los hongos se reproducen por esporas y por efecto del aire se mueven por el ambiente y las superficies, lo que hace que su presencia y propagación por todo el secadero sea creciente, si no se toman las medidas adecuadas.
Varios factores favorecen el desarrollo de estos microorganismos:
La inoculación de microorganismos sobre los alimentos para el proceso de curado corre a cargo de técnicos especialistas de forma controlada, para conseguir los efectos positivos antes mencionados.
Ahora bien, otros microorganismos que no están bajo el control de los especialistas pueden influir negativamente en los alimentos. La colonización indeseada en la superficie de jamones y embutidos se produce a partir de la mico-biota que se transmite por contaminación cruzada desde:
Si no se toman medidas adecuadas, existe un riesgo evidente de seguridad alimentaria, por la posible presencia de micotoxinas tóxicas generadas por algunos de estos microorganismos no deseados, por lo que resulta muy conveniente evitarlos.
Además, los problemas económicos producidos por la presencia de moho no deseado se manifiestan en un incremento de costes por:
4.- Prevención e higiene con pinturas sanitarias y alimentarias
El objetivo por parte del industrial alimentario se ha de centrar en reducir principalmente la concentración mohos, esporas y micelio en:
Una vez más como en otros casos, lo que se desprende de los diversos estudios existentes, es que la prevención e higiene sigue siendo el remedio más inteligente y menos costoso, también contra bacterias y biofilm.
Fakolith hace un aporte de valor con sus pinturas alimentarias y sanitarias con tecnologías FoodGrade para contacto directo e indirecto con alimentos, y con la tecnología BioFilmStop para evitar la anidación de microorganismos en superficies en general, y por lo tanto reducir al máximo la posible contaminación cruzada en este y otros muchos tipos de instalaciones.
5.- Tecnologías innovadoras combinadas: FoodGrade y BioFilmStop
La función primaria que tienen nuestras pinturas alimentarias y sanitarias es obvia, crear un film de pintura funcional de alta resistencia. Adicionalmente las hemos dotado de importantes funciones secundarias, aunque muy importantes, como: el bajo olor con bajos valores VOC, la alta resistencia fisicoquímica, compatibilidad con todo tipo de ambientes, resistentes a lavados y desinfección, su ecología, larga durabilidad, y su resistencia microbiológica conseguida al combinar 3 innovadoras tecnologías clave, en pro de la higiene y seguridad alimentaria.
En la foto adjunta vemos un cultivo del hongo Aspergillus Niger, en el centro una de nuestras pinturas sanitarias tratadas con tecnología BioFilmStop, sobre la que el hongo no puede desarrollarse. En cambio, este hongo se desarrolla rápidamente sobre pinturas convencionales.

TECNOLOGÍA ALIMENTARIA FOODGRADE:

TECNOLOGÍA SANITARIA BIOFILMSTOP GREEN (Artículo tratado BPR Art.3):
TECNOLOGÍA SANITARIA BIOFILMSTOP RED-BLUE (Artículo tratado BPR Art.3):
6.- Guías básicas de Aplicación
En nuestra sección web “Soluciones y guías de aplicación genéricas” encontrará las principales guías de aplicación de nuestros sistemas. En cualquier caso, nuestro departamento técnico puede realizarle sin coste una guía técnica personaliza y adaptada a su empresa.
En este caso, destacamos las siguientes guías genéricas de uso en múltiples sectores de la industria alimentaria, donde el control de mohos y microorganismos, y la usencia de migraciones tóxicas son una prioridad:
Consulte otras soluciones de interés en la misma sección.
7.- El valor añadido que aporta Fakolith
Fakolith es una empresa pionera en pinturas alimentarias y sanitarias. SI bien nuestra firma tiene más de 50 años, fue en 2009 cuando nuestra inquietud por la higiene y seguridad alimentaria nos llevó al desarrollo de las innovadoras tecnologías FoodGrade y BioFilmStop. Desde entonces nos hemos posicionado como el primer fabricante del sector que cumple con todas las regulaciones vigentes y aplicables a esta nueva especialidad, aportando a nuestros clientes un gran valor añadido:

8.- Links de interés
Folleto Pinturas alimentarias y sanitarias certificadas
Folleto Higiene en Industria Cárnica con pinturas alimentarias y sanitarias
Recomendación de la Asociación Federal alemana de Inspectores de Industria Alimentaria
Suscríbase a nuestro boletín de noticias técnicas y permanezca informado